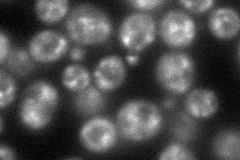
YER122C
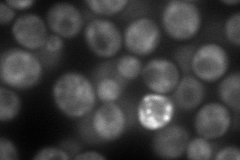
YER122C
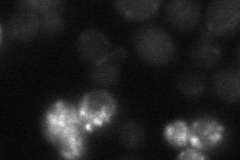
YER122C
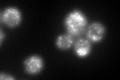
YER122C
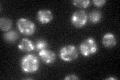
YER122C

View description
ADP-ribosylation factor GTPase activating protein (ARF GAP), involved in ER-Golgi transport; shares functional similarity with Gcs1p
Localization:
Intensity:
Fold change:
Significance:
-
C’ GFP library in SD

punctate78.09 -
N' NOP1pr-GFP in SD
punctate125.176 -
N' TEF2pr-mCherry in SD
cytosol,punctate152.653 -
N' NATIVEpr-GFP in SD
below threshold18.8903 -
N' TEF2pr-VC and Cyto-VN in SD

cytosol57.4065 -
C’ GFP library in SD+DTT
punctate99.571.27No -
C’ GFP library in SD+H2O2

punctate89.321.14No -
C’ GFP library in Starvation Media
punctate74.640.95No -
C’ GFP library on the background of Pup2-DaMP

punctate -
C’ GFP library on the background of CCT mutant

punctate98.81571.26518No
